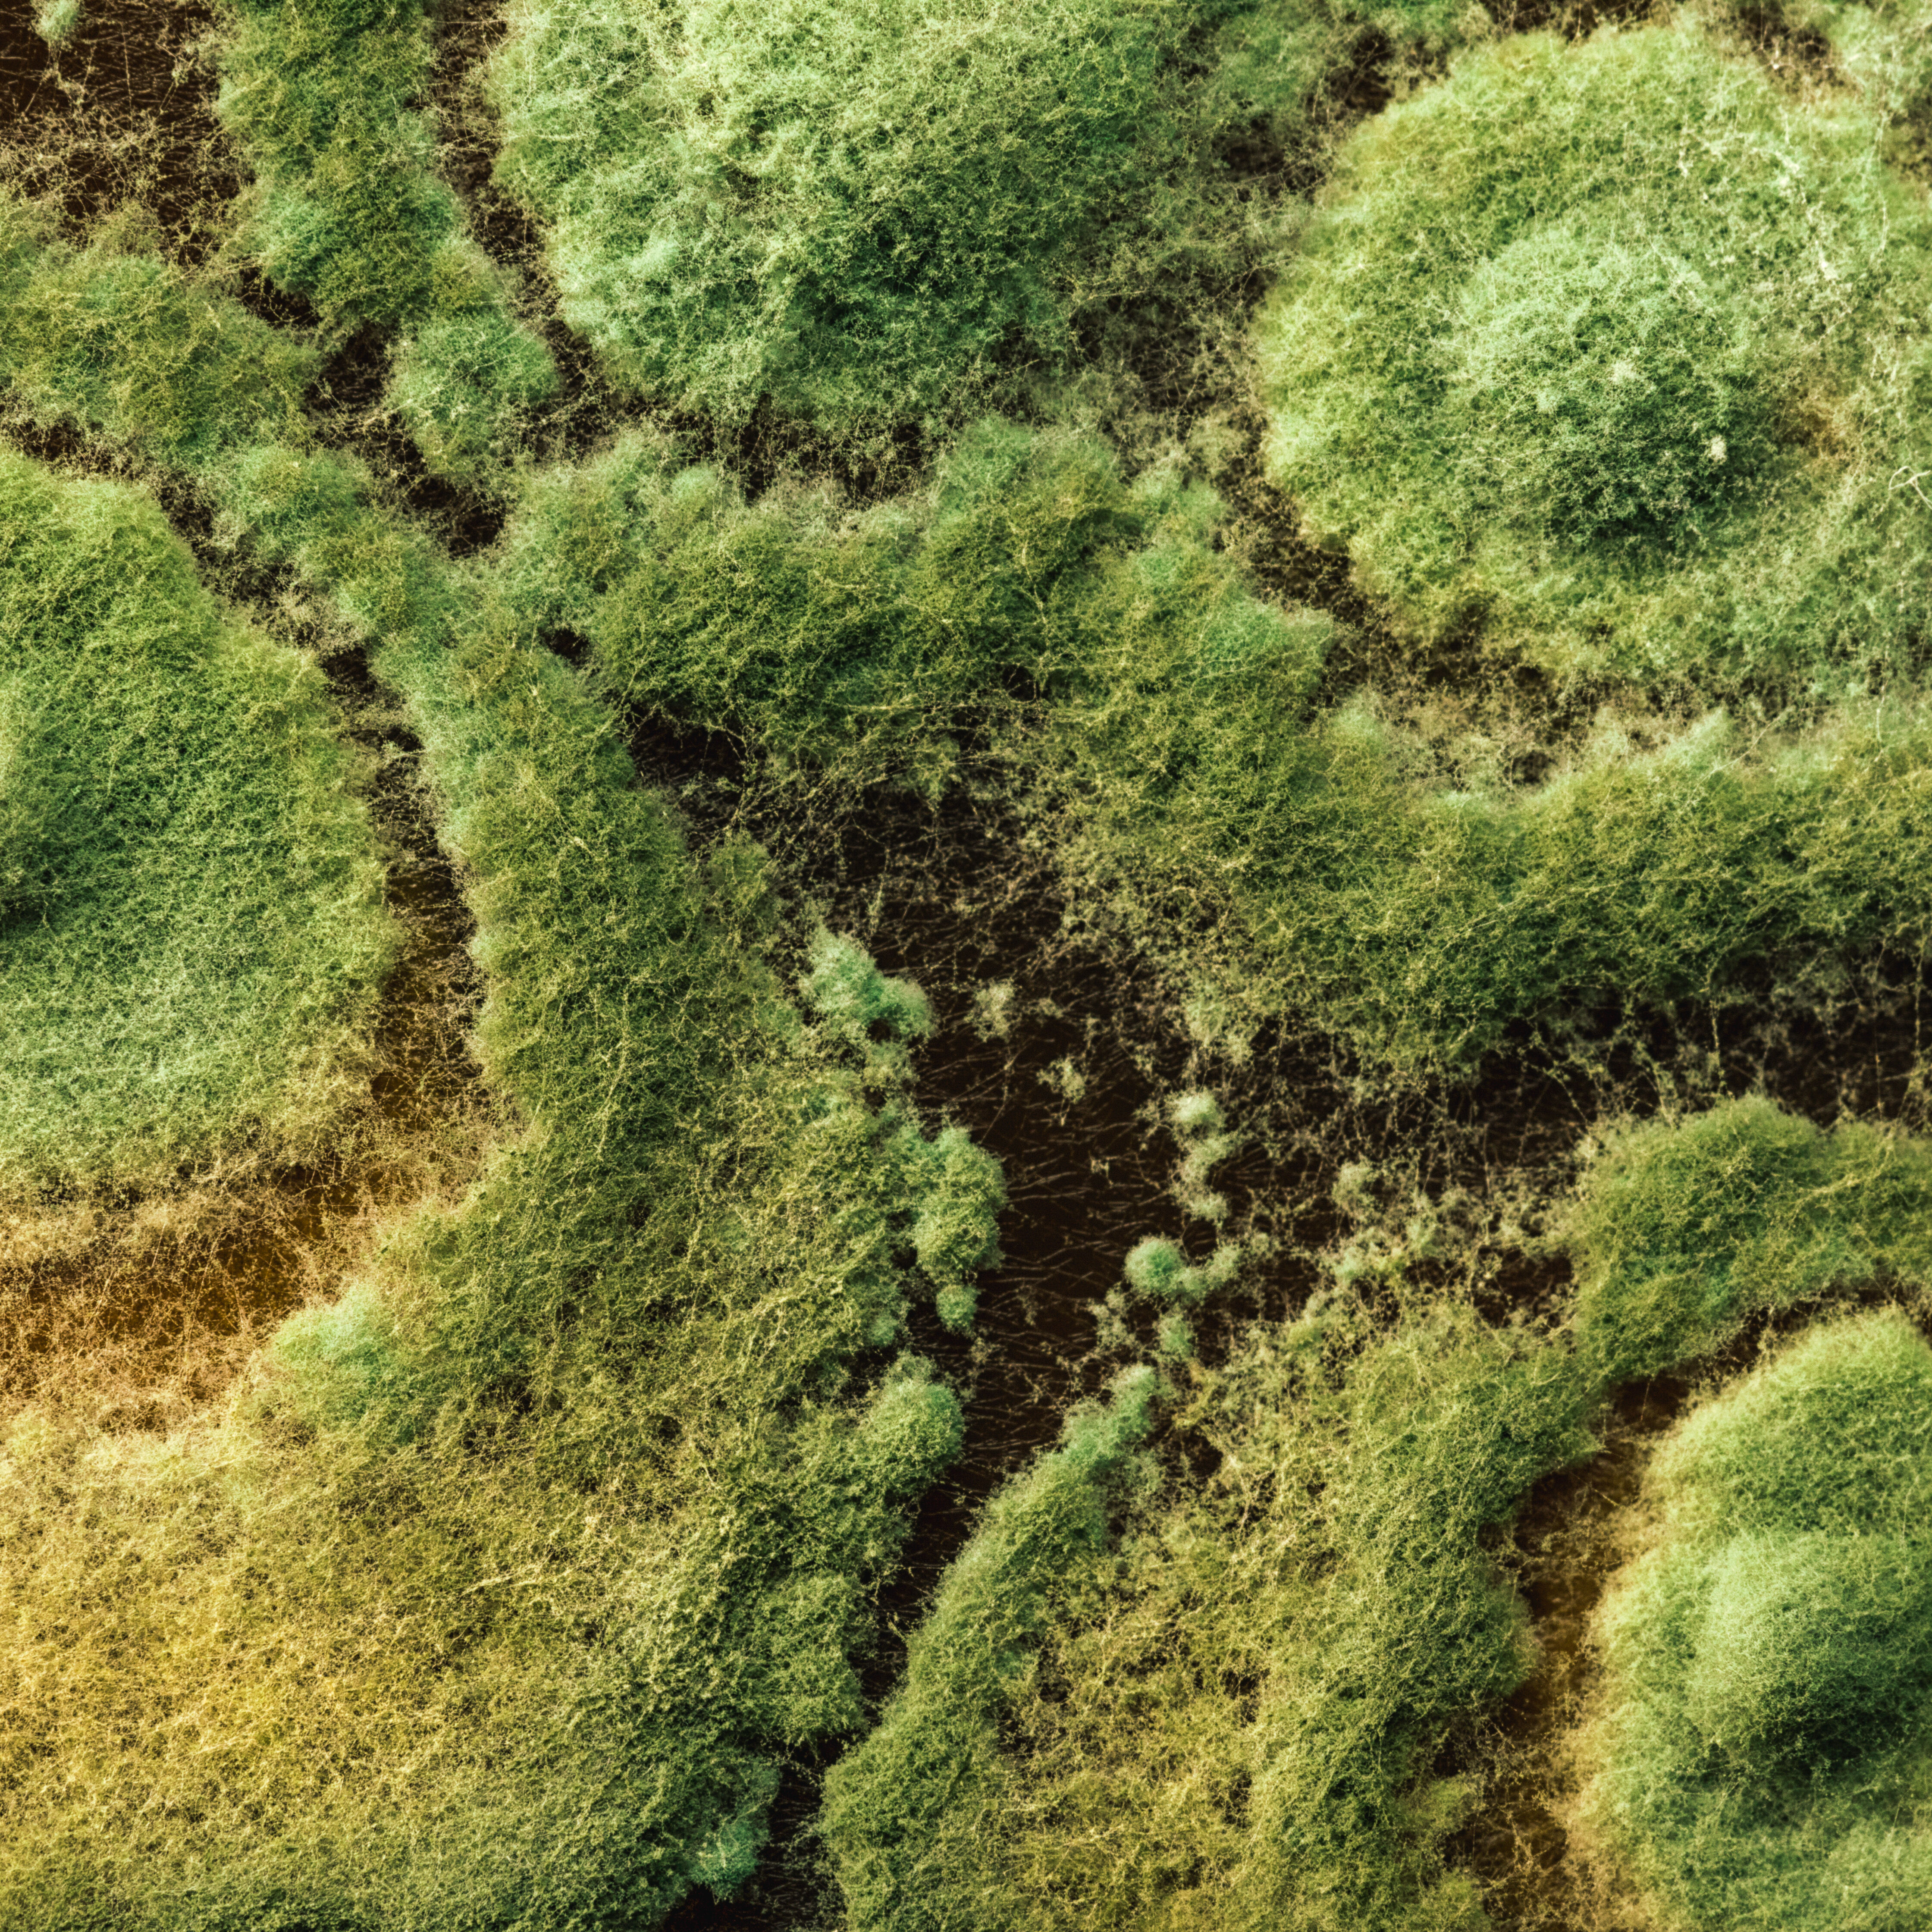

Application
Triario® WG can be applied via planter box (on-site), as a commercial seed treatment, in-furrow spray, and transplant starter solution. Check the label for each crop and situation. Apply Triario® WG as early as possible to the crop for optimal effect.
The application of Triario® WG depends on the crop and use. Check the label to find the Directions for Use for each crop and situation.
Consult a Koppert advisor or a recognized distributor of Koppert products for advice on the best strategy for your situation.